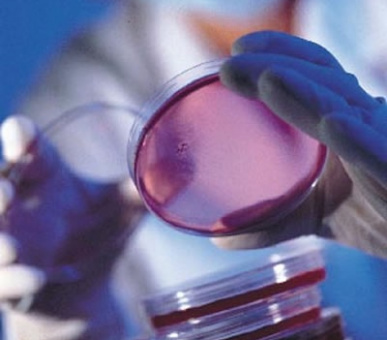
Фото Clinique Lemana (Монтре, Клиники) 10

Опис готеля
Посада: Клініка Лемана розташована в Монтре в одному готельному комплексі. Royal Plaza Созопольй безпосередньо на узбережжі Женевського озера (з вересня 2002 р., коли раніше знаходиться на території готелю Mirador Mont-Pelerin).
CELLVITAL відомий своїм методом клітинної терапії CELLVITAL, що базується на ін'єкції стабілізованих активних клітин ембріону для підвищення імунітету, загальної омолодження, підвищення пружності шкіри, запобігання захворювань, пов'язаних з вікінгом організму, запобігання простих захворювань, підвищення ефективності.
Хвороби клініки Папи П'є XI, Winston Churchill, R. Harrison, Conrad Adenauer.
Історія:
Вперше клінічна терапія була розроблена швейцарським професором Павлом Ніхансом в 1931 році. Добро багато років з медичним лікарем, Альфредом Пфастером, Павлом Ніхансом, виявив, що тварини &апо; ембріони є кращими донорами для клітинних рослин, які мають високу стійкість і стійкість. Метод клітинної терапії був збирати біологічно активні клітини з ембріонів тварин (вівця) і вводити їх у людей не пізніше двох годин після забору, щоб клітини зберігали свої властивості. У такий короткий час не вдалося завершити контроль препарату, тому доктор Пфастер почав розвивати власний метод. Впродовж двох років дослідження Д. Пфастера, у співпраці з Інститутом Бателя Geneve, було знайдено метод стабілізуючих і консервуючих клітин, CELLVITAL, який був знайдений у 1952 році. Біологічно активні клітини овечого ембріону розміщені відразу після забору в спеціальному розчині CELLVITAL, який зберігає свої властивості при температурі 4 градусів. Коли в 1985 році Мс. Денис де Лое-Пфастер успадкував справу батька, д-р Альфреда Пфістра, CELLVITAL ' s клітинна терапія вже довели ефективність у багатьох тисяч випадках.
Клієнт Леману вирощує своїх За умови тварин постійно контролюється ветеринарними фахівцями, тваринами органічної їжі, гормональними добавками та антибіотиками. Матеріал збирається з
Різні органи овець ембріонів під суворим ветеринарним контролем, вони приймають кров для аналізу перед вибором клітин тварин. Відразу після забору матеріал направляється на контроль трьох Державних лабораторій у Цюріху, Берні та Сан-Тала та четвертий кінцевий контроль здійснюється в лабораторіях CELLVITAL Leman ' власна клініка, всі з яких займає сім тижнів. Виходячи з дослідження університетських лабораторій, сертифікат видається за допомогою новоствореного багато препаратів, тому він відповідає всім вимогам безпеки і ефективності.Клієнт проводить детальне опитування перед введенням клітин.Для оцінки стану здоров’я хворого та апосу пацієнту та персоналізації складу розчинника (для кожного пацієнта обраний окремий склад ін'єкційного клітка матеріалу):
- Біохімічний аналіз крові (150 записів)
- аналіз сечі
- клінічне дослідження
- електрокардіограма
- Алергічне тестування - гістамічні препарати вводяться + контроль клітин - реакція на розчин
- Додаткові опитування проводяться в міру необхідності
Додаткове опитування проводиться в Монреуксі, поблизу центру, за додаткову плату.
Клітинна терапія ґрунтується на стимулюванні та оновленні різних клітин організму після ін'єкцій. Наприклад, при проблемах серця вводять більше клітин овець ембріону.
Для досягнення максимальних результатів в клініці використовуються такі умови:
- У клініці «Леман» хворий напроваджується.
- лікування повинно бути під постійним медичним наглядом
- У клініці працює вторинний медичний персонал
Пацієнти можуть приїхати з родинами, як клітинна терапія проводиться в одному з найбільш розкішних готелів Швейцарії, Royal Plaza Hotel. Всі номери та номери в цьому готелі з гарним видом на озеро обладнані кондиціонерами, міжнародними телевізійними каналами, відео, міні-барами, дистанційним керуванням освітленням, прямими лініями для телефону, факсу та Інтернету. Три ресторани, Royal Plaza, мають міжнародну репутацію, і є два комфортабельних бари.
У 4 дні ін'єкцій немає:
- Активний спорт
- приймати ін'єкційний масаж (за 24 години після ін'єкцій)
- Візьміть гарячі туби (допускається)
- відвідування сауни
- До термічних зашифрованих процедур (таласо)
- Я не знаю.
Ефект клітинної терапії починається в основному через чотири шість місяців після введення. У рідкісних випадках наслідки можуть початися тільки один рік після терапії. Після ін'єкцій протягом двох тижнів один місяць може бути втоми (не всі пацієнти) в результаті " відновлення " . Можливості
вторинні ефекти - локальні: фарбування, ущільнення, впорскування, локальні болі; і загальний: підвищена температура, краплі шкіри, діархія, анафілактичний шок (не ще повідомлено) і пізня реакція після розряду.Терапія може початися у віці 30, залежно від способу життя і роботи пацієнта. Повний курс можна повторити кожні 2-3 роки, міні-дискулярний (2 ін'єкції) можна зробити між курсами.
Клітинна терапія:
- Загальна фізична і психічна втома
- Синдром десертифікації
- Вплив важких захворювань і хірургічних втручань
- передчасне старіння і погіршення роботи певних органів і систем організму: мозку, серця, легенів, печінки, нирок, шлунково-кишкового тракту, сечової системи
- Дегенерація з'єднувальних тканин і засобів підтримки (артроз)
- Ендокрин дисфункція
- Синопауза пов'язані ускладнення
- часті захворювання холоду
- зниження ефективності
- Вегетативний розлад нервової системи через стрес
- Хронічні болі: мігрені, недбалості, болі в спині, Ішіас
- Машинна та серцево-судинна система
Проти:
- всі аутоімунні захворювання
- Всі гострі інфекційні захворювання
- Всі пацієнти, які приймають лікування при імунних захворюваннях
- свінгери
- Алергічні пацієнти, які отримують гідрокортизон, не допускаються до відвідування.
Якщо обстеження визначає, що курс проти пацієнта (наприклад, якщо спостерігається сильна алергічна реакція) - значення курсу повернуто тільки вартість обстеження.
Що робить CELLVITAL так унікальний?
CELLVITAL ' s клітинна терапія відноситься до профілактичної медицини, вона показана не тільки при перших ознаках старіння, але може застосовуватися самостійно з хворого &апо; s вік. Ця терапія впливає на певні органи або ендокринні праски протягом багатьох місяців або років, залежно від здоров'я і віку пацієнта.
CELLVITAL клітинна терапія є внутрішньом'язовим введенням активного клітинного блоку,
береться з органів і ендокринних фертів овець для стимулювання і відновлення життєдіяльності клітин організму.Керівник центру охорони здоров’я клініки Леман пропонує Вам додаткові медичні послуги:
Випадковий (Botox)
Який ефект від Vistabel?
- Відчуття і розслаблення обличчя, що дає йому спокійний і чіткий вигляд. Це безпечне і ефективне лікування, розслаблення м'язів і розбиття зморшок. Через 48 годин
Які зморшки можна клеїти з Vistabelle?
- П'єтбелле особливо рекомендується для задоволення "
Хто має право лікувати Vistabel?
- Лікарі-дерматологи і фахівці пластичної хірургії.
Склеротерапія
Хто терапія?
- Для людей, які страждають усадкою розширення вени. Вен кип'ятять і діють на ноги, ікра і стегна.
Терапія
- Вприскування глазурування призводить до з'єднання зв'язування тканин зв'язування вен сегмента, компресів і ущільнювачів вени, тому вени припиняють виконувати. Це відноситься до середини калібру і поверхневого арифтичного розширення вени.
Проксимус
- Нейропастові етикетки призводять до першого разу початковий етап нейропатії стека на стадії аварії нервової автономної системи.
Завдяки цьому ранньому відкритті ви будете підтримувати рухливість і стійкість протягом років і уникнути можливої ампутації ніг або ніг.
Royal Plaza Montreux "
Grand rue 97 Ch-1820 Монреукс
Case Postale 347 Ch-1815 Clarens Швейцарія
0 товар(ов) - 0.00 р.41 (0) 21 961 38 1241 (0) 21 961 38 12
Факс: ++ 41 (0) 21 961 38 13
Веб-сайт: www.lemana.com